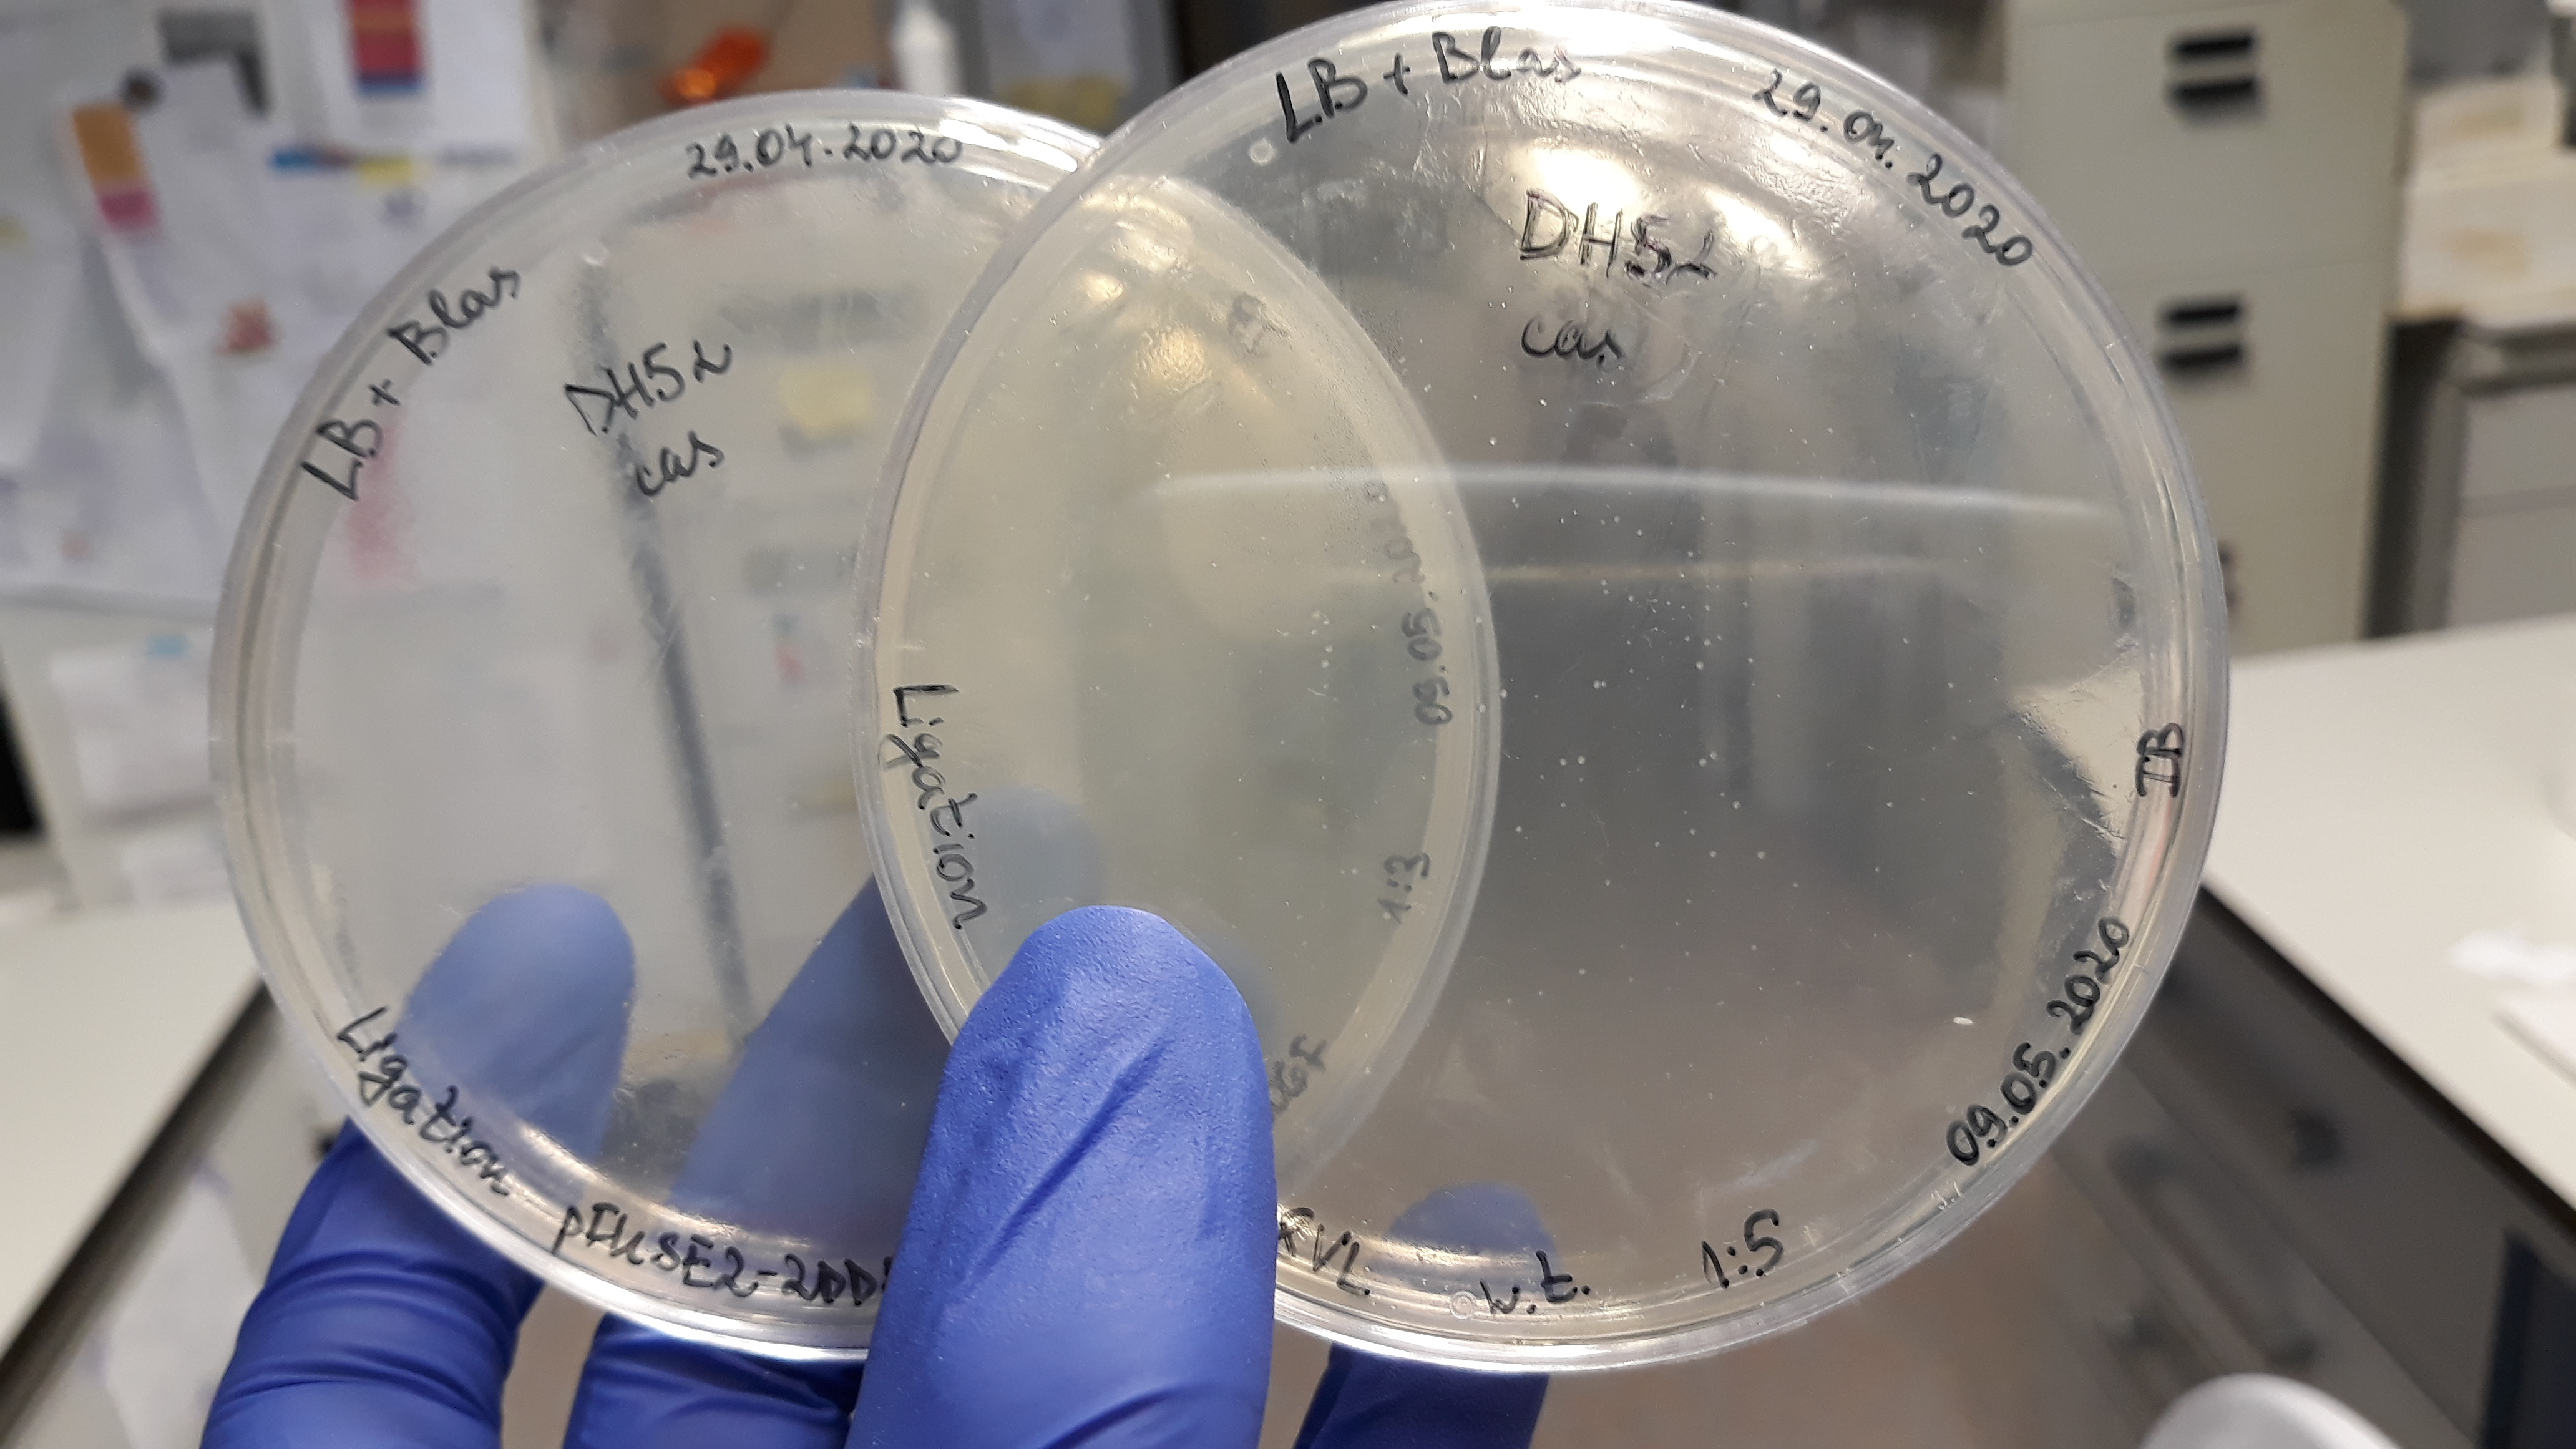

Maya Dimitrova
Maya Dimitrova
 Maya Dimitrova
Maya Dimitrova
 Maya Dimitrova
Maya Dimitrova
 MCAA Management
MCAA Management
How are you doing the pandemic?
6 Comments
Dear all,
Like other I work from home. I discovered sports like yoga and zumba. My family and I rediscovered board family games.
Hi, all! It is nice to hear from you! I am pretending to work at home but actually I am living in a kindergarden+ a nursery, so I just tried to keep some deadlines or to postpone others. Many conferences and my fieldwork trips were canceled, so... regards from the "town" of Dve mogili! I hope to have the opportunity to see you soon and to have a nice time together! (I just cleaned my notebook of biscuits and coontinued pretending ;) )

Greetings to everyone from my lab in Madrid!
I guess unlike most of us I got the luxury (but also the risk) of going out of confinement after two weeks of unsuccessful attempts to be productive and work from home. My lab got approved and granted funding for a COVID-19 project and I'm currently cloning blocking antibodies against SARS-CoV-2, which two of my colleagues will test in cell cultures and animals. Since it's a big race to develop vaccines against this new virus, weekends aren't spared from work... In Spain the government has started lifting some restrictions, but the cases in Madrid are still high in number (my boss went through hospital treatment), so progression to next phase has been postponed... I wish courage and energy to all of you, and stay in good health!
Best,
Ivaylo
Hello to all!
Hope you are all doing well. My project ended on April 30th, and I managed to come to Belgrade last week (greetings from home-quarantine, I got mandatory two weeks). After two months of being alone in Sofia, I'm finally with my family. These days I'm working on the Technical report... it's going a bit slowly, but I hope I'll become more productive in the coming days. I'm sending you a photo of a rainbow which is made a few days ago from my balcony-office. Looking forward to see you all soon (hopefully)!
Be safe and be careful!

Dear Anna and Ani, All,
Greetings from Nottingham!
It's good to hear that your are keeping well and continue contributing to research development and impact during these strange and challenging times!
For me, if anything, the quarantine has brought more work than before as we (like many others, I guess) had to transfer most processes online, continue delivering towards planned and rapidly emerging deadlines in a 'business as usual' manner, and attend a significantly increased number of meetings (of course, online) on a daily basis. So far so good - it is nice to keep busy and distracted from some other things. I even started exercising more in order to balance the extended hours spent at the computer with some energising physical activities.
Just started working on a new research project and paper with collaborators from the US and China. This is a cross-cultural study on how employees and their organisations manage/support employee wellbeing and performance during and after the COVID-19 quarantine.
Hope you will stay well and safe. Looking forward to hearing from you and meeting you (perhaps next year?).
With best wishes,
Stanimira
Dear friends,
I hope you see these messages by me and Anna. We would like to initiate a kind of forum, where we all can freely share our thoughts and messages (no matter how unimportant they may sound in a differetn situation).
The forum at the MCAA portal is flexible enough, but of course all our posts are visible by all MCAA members. One positive thing is that you receive an e-mail message for any new posts here, unless you change your profile settings. Please, do NOT respond to the e-mail message you will receive by REPLY in you e-mail box. Rather, open the link in the text of the message and log in to the MCAA web-site. If you login before clicking the link in the e-mail message, than you will be directly forwarded to the respond text box in the MCAA portal.
Please, share with us your experience with using the MCAA portal for eventual forum-like communication in our group. If you have experience with other types of forums that are easy to use and you can recommend to us, please let us know. Our Facebook and LinkedIn pages are not very popular among the group members I'm afraid.
As it becomes obvious, we will not be able to organize our Chapter meeting at the end of May this year.
In any case, we would like to hear from you and how you spend ( or better - invest !!! ) your time during the pandemic.
I teach from home since March 8th, and will probably finish this academic year in the on-line format. I've subscribed to LinkedLearning and keep educating myself on the varios tricks and tips for Creating engaging E-learn courses and resources. It is fun !!! - the lack of physical activity is what is missing, but at least my brain eats up enough callories, so that I don't see terible changes on the scales.
Stay healthy and please, keep in touch - WE ARE TOGETHER, despite the restricitons.
Looking forward to hearing from you,
Yours
Anife